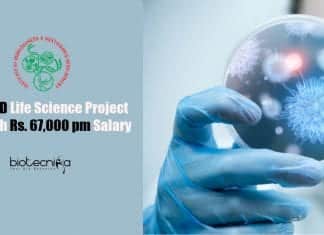
Govt IBSD Life Science Project Jobs With Rs. 67,000 pm Salary Govt IBSD Life Sciences

Scientists To Bring Back Malaysian Extinct Rhinos Using Stem Cells
Reviving Rhinos From Stem Cells To Bring Back The Extinct Species
Malaysia's last Rhino, Iman, died last November after years of failed breeding attempts and...
New Function For A Well-known Molecule As A Plant Hormone
New function of ACC molecule as a plant hormone
A completely new function for a well-known plant molecule called ACC was discovered by the scientists...
Bacteria’s Secret Weapon To Evade Immune Response Revealed
A previously unknown method used by bacteria to evade immune responses has been discovered by the scientists at Monash Biomedicine Discovery Institute (BDI).
Bacterial infections,...
Skin Cancer To Be Tracked Using Urine Sample
Urine test to track progression and treatment response of skin cancer
The most common type of cancer around the world is skin cancer, especially in...
JNTBGRI Junior Research Fellow Job – Botany/Biotech & Bioinformatics
JNTBGRI Junior Research Fellow Job - Botany/Biotech & Bioinformatics
JNTBGRI Junior Research Fellow Job - Botany/Biotech & Bioinformatics. JNTBGRI is recruiting msc candidates for Junior...
Syngene Associate Protein Purification Job – Life Sciences Apply
Syngene Associate Jobs - MSc/MTech Life Sciences Apply
Syngene Associate Jobs - MSc/MTech Life Sciences Apply. Syngene MSc/MTech Life Science Senior Research Associate-Protein Purification Jobs....
Tata Medical Center Biological Sciences Scientific Officer & Project Technician Jobs
TMC Kolkata Biological Sciences Jobs - Scientific Officer & Project Tech
TMC Kolkata Biological Sciences Jobs - Scientific Officer & Project Tech. MSc Biological Sciences...
IISc-Centre for Brain Research Admission For PhD Program 2020
IISc-CBR PhD Admission 2020 - Applications Invited
IISc-CBR PhD Admission 2020 - Applications Invited. Centre for Brain Research (CBR) Full-time PhD Program Admission 2020. Interested...
Biotecnika Times – Newsletter 20.08.2020 – NCBS Msc Trainees Recruitment, Govt...
Biotecnika Times - NCBS Msc Trainees Recruitment, Govt IBSD
Govt IBSD Life Science Project Jobs With Rs. 67,000 pm Salary
Govt IBSD Life Sciences Jobs –...
ICAR-IISR Research Leading to PhD 2020 Under University of Calicut
ICAR-IISR PhD Admission 2020 Under University of Calicut
ICAR-IISR PhD Admission 2020 Under University of Calicut. PhD positions in Botany/Biotechnology/ Microbiology/ Zoology available. Interested and...
AIIMS Delhi Life Sciences Junior Research Fellow Vacancy Available
AIIMS Delhi Latest Vacancy - Life Sciences JRF Job Opening
AIIMS Delhi Latest Vacancy - Life Sciences JRF Job Opening. Junior Research Fellow Job Opening...
ICMR-NIN MSc Biotech Research Associate With Rs. 60,000 pm Pay
ICMR-NIN MSc Biotech Research Associate With Rs. 60,000 pm Pay
ICMR-NIN MSc Biotech Research Associate With Rs. 60,000 pm Pay. MSc Biotechnology & Biochemistry/ PhD...
ICAR-NBPGR Biotech & Life Sciences Project Assistant Vacancies
ICAR-NBPGR Biotech & Life Sciences Project Assistant Vacancies
ICAR-NBPGR Biotech & Life Sciences Project Assistant Vacancies. BSc/BTech Biotechnology & Life Science Jobs. Interested and eligible...
Anna University Biological & Life Sciences Research Fellow Job Opening
Anna University Biological & Life Sciences Research Fellow Job Opening
Anna University Biological & Life Sciences Research Fellow Job Opening. MSc/ MTech Biotechnology, Biochemistry, Biological...
Amazon Launch E-Pharmacy In Bengaluru, Set To Clash Against RIL
Amazon Launch E-Pharmacy In Bengaluru, Set To Clash Against RIL
Hoping to exploit a fast-growing market fuelled by a large base of smartphone users, E-pharmacies...
Scientists Explain Why Some Coronaviruses Cause Deadly Disease While Some Doesn’t
Why don't all coronaviruses cause disease? Scientists explain possible reasons
COVID-19 is caused by SARS-CoV-2, a type of coronavirus that causes infection in the respiratory...
NCBS Genome Engineering Facility Trainees Recruitment 2020 – Apply Online
NCBS Biological Science Jobs - Online Applications Invited
NCBS Biological Science Jobs - Online Applications Invited. MSc. Biological Science Jobs. NCBS Job Opening. National Centre...
Govt Chilika Development Authority Biotech & Microbiology JRF Recruitment
Chilika Development Authority JRF Job - Biotech & Microbiology Apply
Govt Chilika Development Authority JRF Job - Biotech & Microbiology Apply. MSc Biotechnology and Microbiology...
Tata Medical Center Life Sciences Job With Rs. 54,000 pm Pay...
TMC Kolkata Scientist Job - Life Sciences Apply With Rs. 54,000 pm Pay
TMC Kolkata Scientist Job - Life Sciences Apply With Rs. 54,000 pm...
Govt IBSD Life Science Project Jobs With Rs. 67,000 pm Salary
Govt IBSD Life Sciences Jobs - PhD Scientist & Associate Vacancies
Govt IBSD Life Sciences Jobs - PhD Scientist & Associate Vacancies. MSc & PhD...